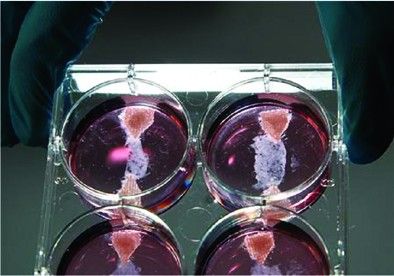
培养皿中两端被夹在尼龙搭扣中的人造肉

波斯特展示人造牛排
培养皿中两端被夹在尼龙搭扣中的人造肉
一块近乎透明的人造牛排,筋络分明,在培养皿中颤动。这般电影中的场景可能在今年10月成为现实。荷兰马斯特里赫特大学的生物工程学家马克·波斯特博士正率领团队,为创造史上第一整块“人造肉”而昼夜奋战。
波斯特的实验室有一只超大号恒温箱,里边的培养皿中躺着一丝丝透明肉类纤维,每条长约3厘米,宽约1.5厘米。产出这样一条纤维,需要500万个细胞。而每3000条肉类纤维才能合成汉堡大小的肉块。波斯特介绍说,做成汉堡大小的第一块“人造肉”,需要25万欧元,并占用2位技术人员一整年的时间。
“造肉”研究跨越世纪
早在80余年前,科学家就已萌生制作“人造肉”的主意。
荷兰医生威廉·范艾伦是“人造肉”的先驱。他在上世纪50年代就投身相关研究,并在1999年申请到干细胞产肉的技术专利。历经5年时间,项目不了了之。美国南卡罗莱纳医科大学的研究者米罗诺夫利用提取动物的成肌细胞制造过人造肉。历经10多年,他在2011年将火鸡中提取的成肌细胞浸泡在牛血清营养液中,培育出火鸡肉。但他培养的火鸡肉较干,缺少天然火鸡肉的多汁口感。而美国国家航空航天局也已从上世纪90年代开始“人造肉”实验,旨在让宇航员吃上不易腐坏的肉制品。
虽然如此,科学界仍有声音坚持人造肉是可行且必要的。据联合国粮农组织的估算,到2050年,全球人口可能达到90亿。鉴于未来的养殖规模可能无法满足所有人吃肉的要求,“肉荒”之势凸显。
美国密苏里大学访问学者尼古拉斯·杰诺维斯也支持人造肉项目。他指出,大多数肉制品都会遭到细菌的污染,而实验室的人造肉在无菌环境中生产,既不会携带、传播病原体,也不会引起传染病。
技术难关伴随伦理质疑
人造肉要想被视作真正的“肉”,有两道关卡要过:第一是生产过程必须高效,能比肩养殖猪牛羊的效率。第二是味道和口感必须与现有肉类一模一样。这两道关卡给人造肉带来了困难与质疑。
波斯特博士的研究小组利用成年动物的肌肉干细胞,目前可分裂20到30次。也就是说,1个细胞可以分裂成100万个。但由于分裂次数仍然较为有限,波斯特的肉条仍然很小,要达到“人造肉”的标准仍需时日。为此,波斯特想到用电刺激细胞,促进其重新调整的办法,甚至想把肉条改造成甜甜圈的形状,但最终结果要到10月才能揭晓。
英国布里斯托尔大学的杰夫·伍德从口感角度提出了质疑。他认为,人造肉的口感可以用来做酱料较重的菜肴,如意大利面中的碎牛肉,但实验室很难培养出羊排或牛排这类整块肉类的替代品。波斯特也考虑到口感的问题,开始着手两个新项目,一个是培养脂肪组织,另一个是增加肉中的肌红蛋白含量,提升肉的口感。
澳大利亚莫纳什大学的伦理学者罗伯特·斯帕罗博士却认为科学家沉溺幻想,忽视了食品的社会和情感意义,“真正应当做的是恢复食物生产的多样性,并采用更加生态、友好的农业生产方式。”
因为技术难点和伦理质疑,人造肉研究很难筹措资金。不过波斯特透露,目前已得到一位美国人资助,其身份将会在今年10月公开。
今年10月,一位知名大厨将在全球媒体面前烹饪波斯特培育的“人造肉”。届时,一切谜团将会揭晓答案。(傅盛裕)
